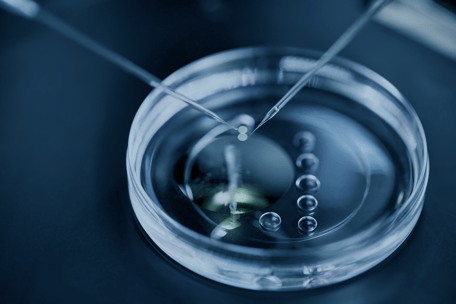

マウス・ラット等さまざまな実験動物の血液検査(CBC)と血液生化学検査の受託を開始いたします。
動物実験センターHPの利用者用サイトに受託サービスの申込ページを開設しました。
「実験動物血液検査サービス」よりお申込みください。
受付後に専用のヘパリンチューブをお渡ししますので、センター受付までお越しください。
検査当日、約150µl以上の血液を入れたチューブをご用意いただき、担当までお渡しください。
¥500/sampleです。
検査機器はVetScanです。
検査項目(CBC)は添付写真の通りです。
詳しくは下記ホームページをご覧ください。
https://cscjp.co.jp/csc-medical/products/hm5.html
血液生化学検査は下記HPをご覧いただき、ご相談ください。
(各自で解析用のカートリッジをご用意いただき、センターで解析する流れになります)